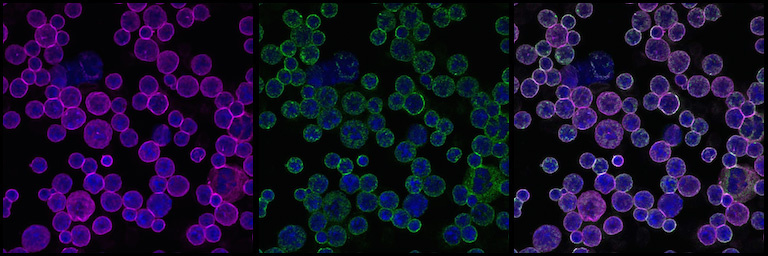

Localization of Nuclear Lamina
Localization of Nuclear Lamina
Submitted by Heejo Cjoi in the Lodish Lab at the Whitehead Institute
"After detecting changes in the dynamics of nuclear lamina expression during terminal erythroid differentiation of mouse fetal liver cells, we were curious as to the corresponding localization of the of these lamins over time – in other words, where on the nuclear envelope are the lamins positioned. Through [this work] we learned that changes in nuclear lamina thickness may explain the resulting dynamics in nuclear lamin expression we previously observed. We were [also] able to notice an important relationship between the areas of high DNA and lamina density by costaining nuclear DNA with lamin proteins. These images show liver cells stained for Lamin A (green), Lamin B (pink), and DNA for reference (blue)."